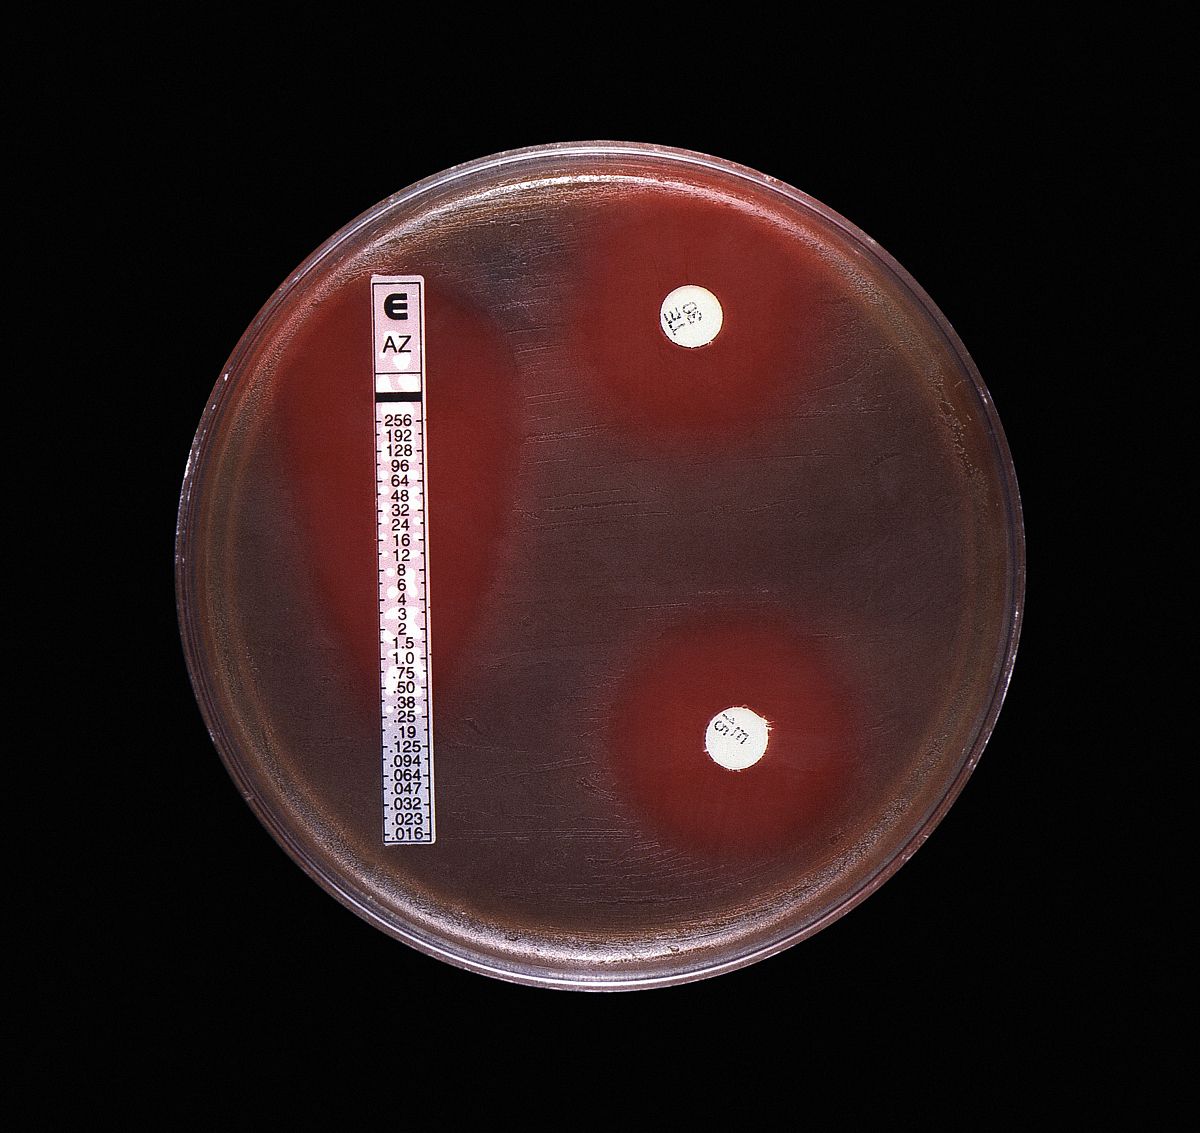
目前,临床微生物实验室进行药敏试验的方法主要有纸片扩散法,稀释法

药敏纸片

杆菌肽药敏实验纸片
图片尺寸650x590
奥复星药敏纸片氟嗪酸氧氟沙星泰利比妥
图片尺寸500x370
杭州微生物 s1100 药敏纸片 成套纸片 10种 20种 30种*20片2f瓶 10种*
图片尺寸800x800
利飞驰liofilchem抗生素药敏实验纸片,微生物鉴定纸片,真菌药敏纸片
图片尺寸318x318
药敏纸片细菌药敏试纸细菌真菌微生物科研成套纸片实验室 b053_0.
图片尺寸800x800
奥普托欣药敏纸片(optochin) 5 ug/片 20片-阿里巴巴
图片尺寸800x800
目前,临床微生物实验室进行药敏试验的方法主要有纸片扩散法,稀释法
图片尺寸1200x1133
空白药敏纸片 空白药敏试纸 6mm 实验室用品 100片/包
图片尺寸800x800
兽药药敏检测纸片意大利liofilchem抗生素实验纸片kb法贴片抑菌
图片尺寸4724x4724
药敏纸片(非注册品种)
图片尺寸9882x6588
杆菌肽药敏纸片图
图片尺寸1800x1668
50片/支 制霉菌素药敏纸片(nys)
图片尺寸567x384
药敏纸片 细菌药敏试验 20片/瓶 可开票10种/20种/30种成套杭微
图片尺寸800x800
纸片扩散法测定细菌药敏试验步骤
图片尺寸864x486
比克曼药敏纸片药敏试纸空白药敏纸片细菌真菌微实验20片/瓶 红色
图片尺寸800x800
药敏纸片时厚4mm这个mh平板的厚度也是有标准的专门做药敏的而是mh
图片尺寸1080x1440
生物药敏纸片10/20种/30种*20片成套药敏试纸细菌药敏试纸 10种*20片
图片尺寸800x800
空白药敏纸片实验室检测微生物细菌圈扩散法kb法滤纸片无菌空白药 6x
图片尺寸800x800
康泰bio-kont 抗生素药敏纸片,鉴定用纸片,微生物药敏试条(扩散法)
图片尺寸951x951
比克曼生物药敏纸片实验室试纸用卡那霉素青霉素泰妙菌素20片/瓶
图片尺寸800x800